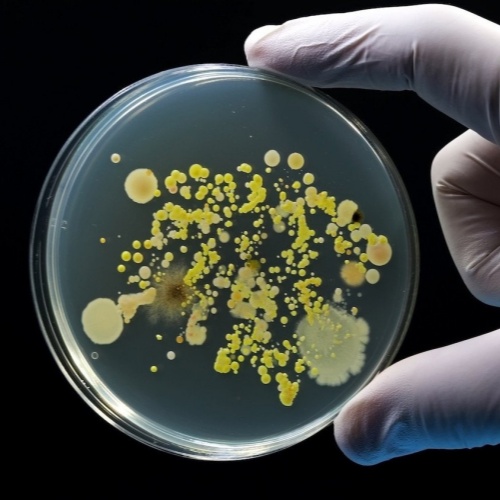

近年来,德国抗生素使用情况呈现出明显变化。根据德国法定医疗保险医师服务中央研究所(ZI)的分析,与15年前相比,医生如今开具抗生素处方的频率明显降低。自2010年以来,抗生素处方总量下降了将近四分之一,约减少24%。这一趋势反映出抗生素使用日益趋于谨慎,也体现了抗菌药物合理使用理念的逐步落实。
总体处方量持续下降
数据显示,2010年德国每1000名法定医保参保人中,平均有559张抗生素处方;到2024年,这一数字降至426张。这一长期下降趋势说明,抗生素的使用正在逐步从“相对宽泛”向“更有指征、更精确”的方向转变。
这种变化与医学界近年来不断强化的抗菌药物管理措施密切相关,包括临床用药指南的更新、耐药性监测的加强以及公众对抗生素滥用危害认知的提升。
疫情期间处方量大幅下降
抗生素处方量下降最为明显的阶段出现在新冠疫情期间,尤其是2020年和2021年。
2020年,每1000名参保人仅有305张抗生素处方;2021年进一步降至277张。作为对比,2019年的数据仍为414张。
ZI分析认为,这一骤降可能与当时呼吸道病原体整体流行减少有关。疫情期间的社交限制、口罩使用和卫生措施,不仅抑制了新冠病毒传播,也显著减少了流感病毒、呼吸道合胞病毒等其他常见呼吸道感染的发生,从而间接减少了抗生素的处方需求。
在年龄分布上,处方下降最明显的是2至5岁以及6至9岁儿童。这些年龄段儿童平时呼吸道感染较为高发,因此在感染减少的情况下,抗生素使用量也随之显著下降。
疫情后出现回升,但总体仍较克制
在疫情后几年,抗生素处方量在各年龄组中均有所回升,整体水平逐渐接近2019年的数据。但不同年龄段变化并不一致。
值得注意的是,6至14岁儿童在2023年和2024年获得抗生素处方的频率,甚至明显高于2019年。相反,1岁以下婴儿的抗生素处方率却下降了约20%。这可能反映出儿科用药策略更加谨慎,尤其是在婴幼儿这一对药物不良反应更为敏感的人群中。
儿童感染增加或是回升原因之一
ZI对学龄儿童处方增加给出了一种可能解释:在2022/2023和2023/2024两个冬季,儿童和青少年中链球菌、支原体以及百日咳感染的发生明显增多。这些病原体中部分属于细菌或需要针对性抗菌治疗,从而带动了抗生素处方上升。
这提示我们,抗生素使用量的变化并不单纯取决于用药观念,还与当年实际感染流行状况密切相关。
德国在国际比较中处于较低水平
ZI管理层指出,德国近年来抗生素使用趋势总体符合欧洲整体走向。从国际比较来看,即使在疫情后的回升阶段,德国的抗生素使用水平仍然相对较低,属于较为克制的国家之一。这在一定程度上说明抗菌药物管理策略取得了成效。
氟喹诺酮类药物处方显著减少
报告中特别提到,氟喹诺酮类抗生素的处方率大幅下降。这类药物虽然对多种细菌有效,但近年来因可能引发严重不良反应(如肌腱损伤、神经系统症状、心律异常等)而受到多次安全警告。因此,医生在选择时更加谨慎,只有在明确适应证且其他药物不适用时才考虑使用。
合理使用抗生素仍是关键
专家强调,抗生素在严重细菌感染治疗中不可替代,但其有效性正受到细菌耐药性扩散的威胁。没有明确指征的抗生素治疗,会增加耐药菌产生和传播的风险,最终削弱药物疗效。
目前的数据表明,德国绝大多数门诊医生在使用抗生素时已相当谨慎,并在充分权衡风险与收益后才开具处方。这一趋势对于延缓耐药问题、保障未来治疗手段具有重要意义。
科普提示
公众也应认识到,抗生素只对细菌感染有效,对普通感冒、流感等病毒感染通常无效。遵医嘱用药、不自行购买或提前停药,是每个人都能参与的“抗耐药行动”。